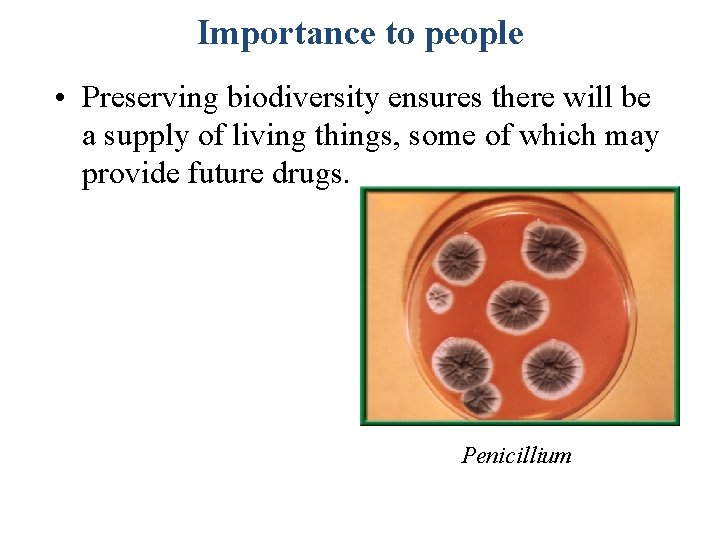
Importance to people • Preserving biodiversity ensures there will be a supply of living

Biological Diversity Biodiversity refers to the variety of

Biological Diversity • Biodiversity refers to the variety of species in a specific area. • The simplest and most common measure of biodiversity is the number of different species that live in a certain area. • Think Pair Share: Identify the area with the most/least biodiversity

Where is biodiversity found? • Think Pair Share: what part of the planet would you expect to find the most biodiversity? The least? . • Areas around the world differ in biodiversity. • Biodiversity increases as you move toward the equator.

Where is biodiversity found? • Tropical regions contain two-thirds of all land species on Earth. • The richest environments for biodiversity all seem to be warm places: tropical rain forests, coral reefs, and large tropical lakes.

Importance to nature • Living things are interdependent. • Living things can be niches for other living things. • Populations are adapted to live together in communities.

Importance to nature • Scientists now know that if a species is lost from an ecosystem, the loss may have consequences for other living things in the area.

Biodiversity brings stability • More biodiversity = more stability. • A pest could destroy all the corn in a farmer’s field, but it would be more difficult for it to destroy all the corn (or representative species) in a rain forest.

Importance to people • Humans depend on other organisms for their needs. • only a few species of plants and animals supply the major portion of the food eaten by the human population. • Biodiversity could help breeders produce additional food crops.
Importance to people • Preserving biodiversity ensures there will be a supply of living things, some of which may provide future drugs. Penicillium

Loss of Biodiversity • Extinction: disappearance of a species when the last of its members dies. • a natural process Earth has had several mass extinctions during its history.

Loss of Biodiversity • always a level of natural extinction (background extinction) • estimated that background extinction ~ 1 – 10 species/yr. • !! current rate exceeds that by many times.

Loss of Biodiversity • endangered species: when numbers so low extinction is possible.

Loss of Biodiversity • When a species is likely to become endangered, is threatened.

Threats to Biodiversity • One biggest reasons for decline Habitat loss in biodiversity.

Habitat fragmentation • the separation of wilderness areas from other wilderness areas.

Habitat fragmentation contributes to: • increased extinction. • changes in biodiversity. • disruption of ecological processes. • invasions by exotic species. • risk of fire.

Habitat fragmentation • smaller fragment = less biodiversity. • Geographic isolation can → genetic isolation. • makes recolonizing difficult.

Edge effect • Conditions at the edge of a habitat are different from those within. • Organisms might be exposed to new organisms or abiotic conditions (predators, prey, temperature, light, plant life) • When an edge changes, animals might migrate because there isn’t enough space from which to gather food.

Habitat degradation • habitat degradation the damage to a habitat by pollution. • air, water, & land. • Pollutants enter atmosphere in many ways —volcanic eruptions, forest fires.

Habitat degradation • Burning fossil fuels is source of air pollutants like sulfur dioxide. • Acid precipitation—rain, snow, sleet, and fog with low p. H values—linked to damage of forests and lakes.

Habitat degradation • ozone layer absorbs sun’s ultraviolet waves reducing the UV radiation reaching Earth’s surface. Click image to view movie. • synthetic chemicals like chlorofluorocarbons (CFC’s) react with ozone to create “holes” in its layer.

Water pollution • Water pollution degrades aquatic habitats in streams, rivers, lakes, and oceans. • can affect aquatic life.

Water pollution • Excess fertilizers and animal wastes are carried by rain into streams and lakes. • The sudden availability of nutrients causes algal blooms, the excessive growth of algae, which decreases oxygen levels.

Land pollution • solid waste, cans, bottles, paper, plastic, metals, spoiled food, cleaners, or paint may contain chemicals that leach into soil and ground water. • Solution: Recycling Click image to view movie.

Land pollution facts • The average American produces ~ 1. 8 kg of solid waste daily. • ~ 657 kg of waste/person/yr. • some may decompose, most becomes solid waste buried in landfills.

Land pollution • The use of pesticides and other chemicals can also lead to habitat degradation.

Exotic species • People may introduce a new species to an ecosystem. • can cause problems for native species. Kudzu

Exotic species • When exotic species are introduced, can grow faster because are not as vulnerable to local competitors or predators as native species. • Example: exotic snakes in Florida

Question 1 The term that refers to the variety of species in a specific area is _____. A. ecology B. conservation biology C. biodiversity D. endangered species

The answer is C. The simplest measure of biodiversity is the number of different species that live in a certain area.

Question 2 Describe the possible effect on a biological community of removing one species.

Because living things are interdependent, removing a single species from a community can remove a food source or otherwise break symbiotic relationships causing remaining organisms to suffer. This decreases the stability of the ecosystem.

Question 3 When the population of a species begins to significantly decline in numbers, it is _____. A. threatened B. extinct C. fragmented D. diverse

The answer is A. When the population of a species is declining and likely to become endangered, it is said to be a threatened species. Results of Species Search* Scientific Name Common Name Loxodonta africana African elephant Group Mammals Listing status Current Range T Africa *U. S. Fish & Wildlife Service Threatened and Endangered Species System (TESS) Through the Fish and Wildlife Service, information is available to the public on all species threatened or endangered T, under Listing Status, refers to threatened. An E would indicate endangered.
- Slides: 33